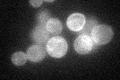
YER020W
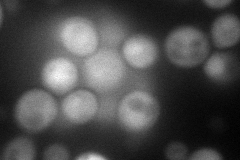
YER020W
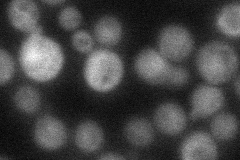
YER020W
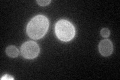
YER020W

View description
Nucleotide binding alpha subunit of the heterotrimeric G protein that interacts with the receptor Gpr1p, has signaling role in response to nutrients; green fluorescent protein (GFP)-fusion protein localizes to the cell periphery
Localization:
Intensity:
Fold change:
Significance:
-
C’ GFP library in SD
cell periphery31.84 -
N' NOP1pr-GFP in SD

cytosol0 -
N' TEF2pr-mCherry in SD
cytosol94.1805 -
N' NATIVEpr-GFP in SD
cytosol29.1725 -
N' TEF2pr-VC and Cyto-VN in SD

cytosol36.6162 -
C’ GFP library in SD+DTT

cell periphery40.881.28No -
C’ GFP library in SD+H2O2

cell periphery37.621.18No -
C’ GFP library in Starvation Media
cell periphery76.82.41Yes -
C’ GFP library on the background of Pup2-DaMP

cell periphery -
C’ GFP library on the background of CCT mutant

cell periphery28.83450.905289No
